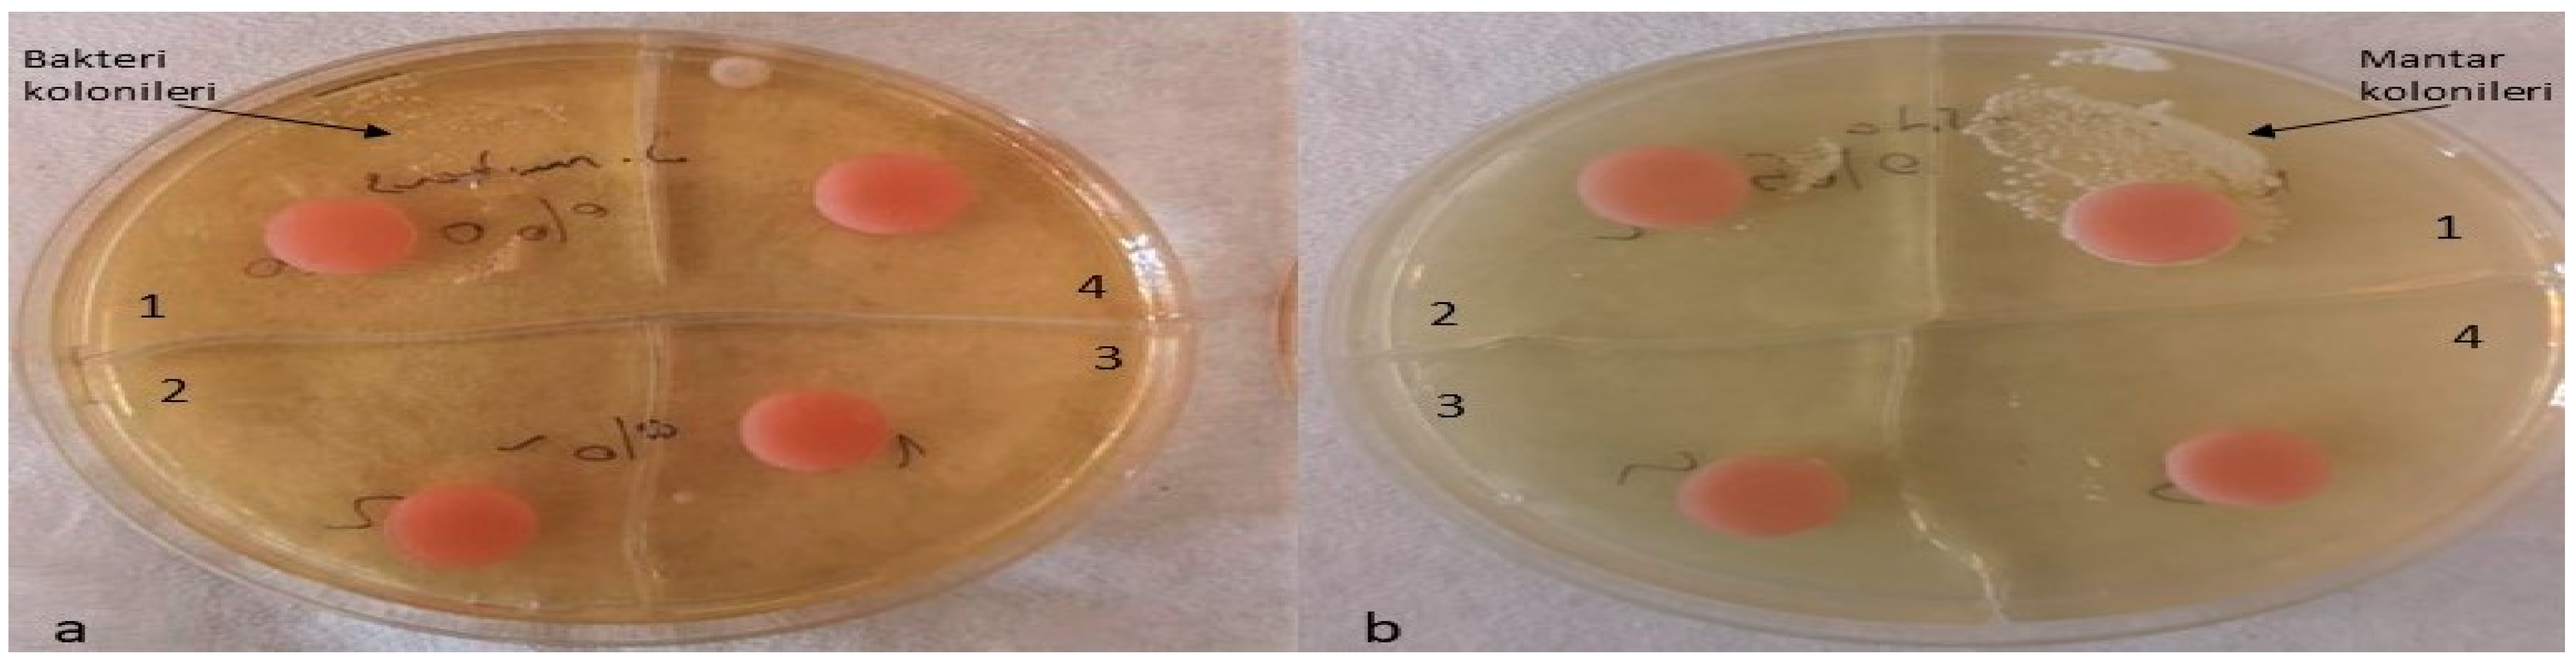
Inorganics 12 00258 g011

Abstract
Background and Purpose: This study aimed to evaluate the flexural strength, color change and antimicrobial effect of silver–zeolite nanoparticles (NPs) in acrylic resin materials. Methods: Fifty-six disc-shaped acrylic resin samples were divided into four groups (n = 7) according to concentrations of silver–zeolite NPs (0%, 2%, 4%, 5%). Discs were contaminated with C. albicans and S. mutans. The antimicrobial effect was tested by inoculating contaminated discs on Tryptic soy agar (TSA), Sabouraud Dextrose Agar (SDA), Tryptic soy broth (TSB), and Sabouraud dextrose broth (SDB). Forty rectangular 65 × 10 × 2.5 mm acrylic resin specimens were also classified into four groups (n = 10) according to concentrations of silver–zeolite NPs. For the color change, L, a, and b values of rectangular specimens were examined with a spectrophotometer. A three-point bending test was also performed using a Devotrans device to determine the flexural bond strength of rectangular specimens. Scanning electron microscope analysis (SEM/EDX analysis) was also performed. Results: In this study, the antimicrobial effect increased with the concentration of silver–zeolite NPs added to acrylic resin discs. In our study, adding 2% silver–zeolite NPs was more effective against C. albicans. The antimicrobial effect against S. mutans increased with concentration of silver–zeolite NPs (<0.001). The colonization of C. albicans was significantly reduced by silver–zeolite NPs. A significant increase was observed in the color change as the nanoparticle percentage ratio increased (p < 0.001). The flexural strength values of the groups containing 2% and 4% nanoparticles were found to be clinically acceptable. Conclusions: The study showed that bacterial and fungal colonization is significantly reduced by adding silver–zeolite nanoparticles to acrylic resin discs. Based on its antimicrobial, physical, and mechanical properties, we recommend adding 2% silver–zeolite nanoparticles to the acrylic resin material for optimal results.
1. Introduction
Polymethyl methacrylate (PMMA) is commonly used in prosthetic dentistry for edentulous patients due to its aesthetic appeal, easy handling, affordability, and stability in the oral cavity. Denture base materials are also widely used in the manufacture of orthodontic removable appliances such as temporary dentures, placeholders, and functional appliances [1]. One of the most common problems is that the space maintainer, while using these appliances, has the potential for plaque accumulation due to their surface porosity and food retention configuration, which increases the bacterial activity of the cariogenic oral flora for patients and dentists [2]. PMMA is considered to be the material of choice for prosthetic base fabrication due to its low cost, water solubility/absorption, and adequate durability. However, some of the disadvantages of this material are its dimensional instability, residual monomer content, and poor mechanical properties, particularly its poor impact resistance. Poor mechanical properties often lead to internal and external fractures of the denture base. Different approaches have been adapted to improve the mechanical and microbiological properties of PMMA denture base material [3]. The insertion of prosthetic devices into the oral cavity affects the oral microflora and results in accumulation of microorganisms on the prosthetic surface. Such fouling of denture surfaces can lead to a number of oral diseases and consequently to the replacement of the denture [4].
The oral cavity is a complex environment where microorganisms compete for space and nutrients. Especially in elderly and immunocompromised patients, these microorganisms can distribute and trigger systemic diseases such as infective endocarditis and aspiration pneumonia, which are the main causes of morbidity and mortality [5]. Since microorganisms accumulate on removable prostheses’ surfaces, they can damage soft tissue and oral health [6], impairing the effectiveness and quality of prosthetic treatment [7]. Although systemic or topical antifungal therapies have been recommended to reduce fungal infection, many barriers limit their use, such as antimicrobial resistance, poor oral hygiene, cost, and the routine of applying proper denture cleaning and strict local treatment [8]. Studies have shown that Streptococcus mutans and Lactobacillus casei may have cariogenic potential due to their acidogenic and aciduric abilities [9]. Oral candidiasis is the most common infection of the oral mucosa in patients (approximately 72%) using full dentures [10,11].
Geriatric patients are unable to provide effective hygiene and care due to poor motor coordination, cognitive impairment, or memory loss [12]. For this reason, clinical trials have been made to prevent or reduce the adhesion and accumulation of microorganisms on the prosthesis surface [13]. The oral microflora is a complex ecosystem that includes a wide variety of microbial species [14]. More than 700 different types of bacteria have been identified in the human oral cavity so far, and most of them are associated with plaque [15]. Bacteria help Candida adhesion to the denture base and mucosa by producing extracellular polymers and increasing acidity, creating optimal conditions for fungal growth. The oral cavity consists of many surfaces covered with a large number of bacteria, and some of them may form biofilm [16]. The aesthetic properties of dental materials have become very popular and essential today. These materials should have a shiny and smooth surface and maintain their smoothness in the oral environment for a long time. Smooth surfaces provide an aesthetic appearance and prevent the formation of the biofilm layer that causes plaque retention. Among the bacterial species in the oral flora, S. mutans plays the most important role in plaque formation since it is the first microorganism to adhere to the surface [17]. Candida species are members of oral flora, and they are commonly responsible for opportunistic infections in the oral cavity. Using glycoprotein adhesins, Candida albicans attaches to the epithelial cells in the mouth, including the buccal mucosa, tongue, teeth, and oral prostheses. Although the conditions for growth in the oral cavity are unfavorable, C. albicans can still proliferate in saliva because it contains glucose [18]. Opportunistic oral pathogens can colonize on acrylic materials and cause dental infections such as denture stomatitis. Currently, it is a common practice to add antimicrobial agents to dental materials. Silver nanoparticles can be added to acrylic resin materials to prevent bacterial colonization by S. mutans, Escherichia coli, and Staphylococcus aureus. In addition to their antibacterial effect, nanoparticle-added acrylic resins have shown antifungal properties against the adhesion of C. albicans [19]. In the design of a removable prosthesis, durability is one of the most important mechanical properties to ensure that the prosthesis is effective, safe, and serves for a reasonable period of time. Flexibility must be high to protect the underlying soft tissues by absorbing masticatory forces. It must have a high elastic limit to prevent permanent deformation when stretched [20]. It must have sufficient mechanical strength to resist fracture under repeated chewing forces. It should be dimensionally stable. It must have adequate wear resistance. In the last two decades, experiments have been carried out involving particles, fibers, and fillers of different shapes, sizes, forms, and orientations [21,22].
Recent advances in nanotechnology, such as nanoparticles, nanofibers, and nanotubes, have been used for PMMA reinforcement [23]. Among inorganic antimicrobial agents, silver nanoparticles have been most widely used to fight infections since ancient times [24,25]. Nano-sized (nm) inorganic particles of silver have rapid and broad-spectrum efficacy due to their sustained release of silver cations (Ag+) [26,27]. This form appears to be more effective compared to micro-sized silver powder (µm), which shows lower antimicrobial activity due to its limited surface area [28].
Silver nanoparticles are one of the most commonly used nanoparticles because of their ductility, electrical and thermal conductivity, and antimicrobial activity [29]. Zeolites are crystalline made of aluminum silicate with void spaces ranging from 3 to 10 angstroms. Antimicrobial cations, such as silver and zinc, can get trapped in zeolite pores and be replaced with other cations from the environment over time [30]. When ions are available, they contact microorganisms and suppress their growth by inactivating enzymes, interrupting RNA replication, and blocking respiration through oxidative stress [30,31]. In dentistry, dental caries and candidiasis are common illnesses in the oral cavity, causing health problems for many people worldwide. Bacteria and yeast in the mouth are responsible for the reason of these conditions. Candida albicans is the most common cause of fungal infections in the oral mucosa, particularly in elderly patients who wear full dentures. Studies have shown that antimicrobial zeolites are effective against aerobic and anaerobic bacteria and Candida species [32,33]. This study aimed to investigate the antimicrobial effect of acrylic resins containing different amounts of silver–zeolite nanoparticles. Drawbacks associated with the use of silver nanoparticles and other silver-based materials include nanoparticle aggregation and deterioration of composite mechanical properties, aesthetic incompatibility due to color changes resulting from the reduction of Ag+ to Ag°, and short-term antimicrobial activity [4]. While improving the mechanical properties of a denture base acrylic resin, it is also of great importance not to compromise its physical properties [34].
This in vitro study aims to investigate the effect of silver zeolite, an antimicrobial nanoparticle, on the microbiological, optical, and mechanical properties of acrylic resin when added to heat-polymerized acrylic resin at different ratios. The null hypothesis of the study is that silver–zeolite nanoparticles added to dental acrylic resins will not have an antimicrobial effect on saliva-contaminated dental acrylic and will not change its mechanical and physical properties.
2. Results
2.1. Surface Topography
The surface topography roughness of the silver–zeolite nanoparticle (NP) samples incorporated into heat-cured acrylic resin was examined using Scanning Electron Microscopy (SEM) (Figure 1). SEM and EDX analysis confirmed the presence of silver–zeolite nanoparticles within the dental acrylic. Surface roughness was assessed through the SEM images, which revealed that roughness increased with higher nanoparticle concentrations compared to the control group (Figure 1). Higher nanoparticle concentrations led to the formation of hollow areas and noticeable indented and protruding surfaces. In the 4% and 5% nanoparticle groups, the pit surface areas significantly expanded (Figure 1). This increased surface roughness, characterized by visible porous structures, could facilitate the colonization of rapid biofilm-forming microorganisms such as Candida. Therefore, it is crucial to carefully adjust the nanoparticle concentration in acrylic resin materials to minimize surface roughness and mitigate potential microbial colonization.
Figure 1.
Surface topography of the discs by SEM images. (A) Control group surface topography (from left to right 300×/500×/1000× magnification); (B) 2% NPs added discs surface topography (from left to right 300×/500×/1000× magnification); (C) 4% NPs added discs surface topography (from left to right 300×/500×/1000× magnification); (D) 5% NPs added discs surface topography (from left to right 300×/500×/1000× magnification).
2.2. Energy-Dispersive X-ray Analysis
Scanning electron microscope and energy-dispersive X-ray (SEM/EDX) analysis (Hitachi S-4100 FE-SEM/EDS, Tokyo, Japan) of Ag-denture acrylic was carried out in a field emission electron microscope attached to an SEM at an accelerated voltage of 20 keV. Energy-dispersive X-ray (EDX) analysis was carried out to determine the presence of elements in the samples from each group (2%, 4%, 5%) containing NPs (Figure 2). As a result of EDX analysis, the calculated atomic percentage of silver was found to be 1.01 in the 2% group. These results confirmed the inclusion of silver in the 2% group in dental acrylic samples. EDX analysis showed 7.14 as the calculated atomic percentage of silver in the 4% group. EDX results also highlighted the presence of silver in the 4% group in dental acrylic samples. As another result of EDX analysis, the calculated atomic percentage of silver was found to be 11.25 in the 5% group (Figure 2). These results also confirmed the inclusion of silver in the 5% group of dental acrylic specimens. As seen in (4%) and (5%) SEM/EDX graphics and images, as the percentage of nanoparticles increased, the displayed amount of silver nanoparticle increased and the presence of silver was proven (Figure 2).
Figure 2.
Ag Images with SEM/EDX in the (A) 2%, (B) 4%, and (C) 5% (respectively, up to down) groups.
2.3. Optical Test Results
In line with the findings of our study, there was a significant difference between the groups in the ΔE2000 color analysis of all groups with each other. A significant increase was observed in the 2%, 4%, and 5% groups compared to the control group (p < 0.001). Compared to the 0% group, the highest color change was observed in the 5% group (Table 1). It was determined that there was a color change with the increase in nanoparticle ratio (Figure 3).
Table 1.
Comparison of ΔE2000 values of heat-polymerized acrylic resin samples according to groups.
Figure 3.
ΔE2000 color change of the groups.
2.4. Flexural Strength Test Results
The Kruskal–Wallis test was used statistically to test whether there was a difference between the average flexural strength values of the groups to which silver–zeolite nanoparticles were added at different rates. The results of this analysis are given in Table 2.
Table 2.
Flexural strength test results by groups.
No significant difference was observed in the mean values between the 2% and 4% groups. There was a significant difference between the groups (p < 0.001). When Figure 4 is examined, it is determined that the average values of the groups containing 2% and 4% nanoparticles were the same, and the strength value was lower than the 0% group. The group containing 5% nanoparticles was found to have lower flexural strength than all groups. In our results, a decrease was observed from 0% (80.28) to 2% (65.40), and no flexural strength change was observed between 2% (65.40) and 4% (65.40). However, the flexural strength decreased in the group in which we increased the nanoparticle ratio from 4% to 5% (Figure 4).
Figure 4.
Flexural strength values of three-point bending strength test.
2.5. SEM Analysis
As a result of the three-point bending strength test, it was observed that the fracture line in acrylic samples increased as the ratio of silver–zeolite nanoparticles increased in the SEM analysis. In general, mirror, mist, and hackle fracture regions are formed in the images on the fracture surface of polymers. The mirror region is the initial stage of fracture, and crack growth is very slow. This region was observed to be very large in the 0% control group (Figure 5a). In Figure 5c, the crack line in the 0% control group is very few and small. In the 0% control group, the fracture line is less pronounced, and the number of cracks is less. A thin mist zone surrounds the mirror zone. When the energy is concentrated in the bifurcation form where the crack line reaches rapid propagation, the hackle zone surrounds the mist zone (Figure 5b/Hackle zone). The number of nano-fractures increased in the 2% group (Figure 6c). When the SEM images of the 4% group were examined, it was observed that the nano-cracks became larger as the nanoparticle percentage increased (Figure 7b). It was observed that there was an increase in nanoparticle agglomeration compared to the 2% group. In the group containing 5% nanoparticles, the hackle zone was enlarged, and the cracks (Figure 8c) were indicated by arrows, and the lines appeared longer and wider.
Figure 5.
SEM Images of Fracture Surface of Control Group 300×/500×/1.00K× magnification: (a) Mist zone, (b) Hackle zone, (c) Nano-crack.
Figure 6.
SEM Images of Fracture Surface of 2% Group 300×/500×/1.00K× Magnification: (a) 2% Ag/Z group agglomeration, (b) 2% Ag/Z group agglomeration, (c) Increase in the number of nano-cracks.
Figure 7.
4% Group Fracture Surface SEM Images 300×/500×/1.00K× Magnification: (a) Increase in the number of nano-fractures, (b) 4% Ag/Z group agglomeration, (c) Increase in the size of nano-fractures.
Figure 8.
5% Group Fracture Surface SEM Images 300×/500×/1.00K× Magnification: (a,b) 5% Ag/Z group agglomeration, (c) Hackle zone expansion, nano-crack length increase.
2.6. Antimicrobial Test Results
Bacterial and fungal colonization on the discs was evaluated using three different methods. First, XTT and PMS solutions were added to the discs, and color changes, which correlated with microorganism concentration, were measured using a spectrophotometer (Figure 9). Second, contaminated discs were inoculated onto TSA and SDA plates, and the results were evaluated after 24–48 h of incubation. Third, discs were incubated in TSB and SDB broth for 6 h, then plated onto TSA and SDA media, with colony counts assessed after 24–48 h of incubation. None of the control groups exhibited antimicrobial activity. For all acrylic resins, the addition of 2% silver zeolite was sufficient to impart antimicrobial activity against the test strains.
Figure 9.
The color differences after XTT and PMS added.
In each well, concentrations were measured using a spectrophotometer. The minimum, maximum, mean, and standard deviation values were obtained by measuring the cell density of C. albicans at a wavelength of 490 nm (Table 3). One-way analysis of variance (ANOVA) revealed a statistically significant difference among the C. albicans groups (p = 0.001).
Table 3.
Measurement of microorganism concentration with spectrophotometer.
The mean fungal concentration in the control group was 0.154, which decreased to 0.119 in the 2% silver–zeolite group. In contrast, the concentrations in the 4% and 5% groups increased compared to the 2% group. Statistically, no significant difference was observed between the 4% and 5% groups and the control group. The acrylic resins with 2% silver–zeolite nanoparticles demonstrated the optimal antimicrobial effect against C. albicans colonization (Figure 10). Additionally, the minimum, maximum, mean, and standard deviation values for bacterial concentration were obtained by measuring S. mutans with a spectrophotometer at 490 nm (Table 3). One-way analysis of variance (ANOVA) revealed a statistically significant difference between the mean values of the S. mutans groups (p < 0.001). Concentration levels decreased with increasing silver–zeolite concentration among the groups (Figure 10).
Figure 10.
Differences in C. albicans and S. mutans concentrations.
The optimal antimicrobial effect against S. mutans was achieved with acrylic resins incorporating 5% silver–zeolite nanoparticles. Contaminated discs were inoculated onto TSA (for S. mutans) and SDA (for C. albicans) media. Discs contaminated with C. albicans were incubated at 37 °C for 24 h, whereas discs contaminated with S. mutans were incubated at the same temperature for 48 h. The control group exhibited no antimicrobial activity. A reduction in the colony number of C. albicans and S. mutans was observed in accordance with the concentration of silver–zeolite nanoparticles incorporated into the acrylic resin discs (Figure 11). Additionally, contaminated discs were inoculated into TSB and SDB media, incubated for 4–6 h, and then 10 µL samples were plated onto SDA and TSA. After 24–48 h of incubation, a substantial decrease in colony numbers was noted, correlated with increasing concentrations of silver–zeolite nanoparticles (Figure 12 and Figure 13). The mean colony number (CFU/mL) of C. albicans is detailed in Table 4.
Figure 11.
Inoculation of contaminated discs with S. mutans and C. albicans. (a) S. mutans, a1 no silver–zeolite NPs added, a2 discs with 2% silver–zeolite NPs, a3 discs with 4% silver–zeolite NPs, a4 discs with 5% silver–zeolite NPs; (b) C. albicans, b1 no silver–zeolite NPs added, b2 discs with 2% silver–zeolite NPs, b3 discs with 4% silver–zeolite NPs, b4 discs with 5% silver–zeolite NPs.
Figure 12.
Colony count of C. albicans strains. 1: no silver–zeolite NPs added (Control group), 2: discs with 2% silver–zeolite NPs, 3: discs with 4% silver–zeolite NPs, 4: discs with 5% silver–zeolite NPs.
Figure 13.
Colony count of S. mutans strains; 1: no silver–zeolite NPs added (Control group), 2: discs with 2% silver–zeolite NPs, 3: discs with 4% silver–zeolite NPs, 4: discs with 5% silver–zeolite NPs.
Table 4.
Colony number of different groups (CFU/mL).
According to the Kruskal–Wallis test analysis, there was a statistically significant difference on the C. albicans colony number between the groups with silver–zeolite NPs and the control group (p < 0.001). As seen in Table 4, there was a significant decrease in the amount of C. albicans, but the bacterial growth did not stop totally. Therefore, C. albicans was found in each group even in a small number. While it was 100,000 CFU/mL in the 0% control group, it was 80,000 CFU/mL in the 2% group; It was calculated as 10,000 CFU/mL in the 4% group and 5000 CFU/mL in the 5% group. The mean values of S. mutans colonies (CFU/mL) are shown in Table 2. According to the results of Kruskal–Wallis test analysis, the groups with silver–zeolite NPs had a statistically significant difference compared with the control group (p < 0.001). According to our results, on average, 100,000 CFU/mL bacteria was found in the control group. There was no bacterial growth in the other groups. Therefore, our results show that silver–zeolite NPs have effect on bacterial growth. As seen in the graphics, the number of S. mutans colonies decreased significantly, and statistically significant difference was found between the control group and the others (p < 0.001).
3. Discussion
Acrylic resins are commonly used for making denture bases due to their easy manufacturing process, low cost, light weight, good appearance, and suitable properties for the oral environment [35]. Acrylic resins used for removable denture bases require improved mechanical properties to withstand repetitive chewing forces in the oral cavity [36]. Studies have shown that the strength properties of acrylic resins can be enhanced by integrating them with fibers, nanoparticles, and nanotubes [4,8,36]. Researchers are still searching for biocompatible nanomaterials to enhance the mechanical and biological properties of acrylic resins [37]. The accumulation of microorganisms that cause denture-associated stomatitis can be caused by surface roughness exceeding the acceptable limit of acrylic resins [38]. It is well established that denture bases made from heat-cured acrylic resin can serve as a breeding ground for microorganisms, leading to recurring infections in denture wearers [39]. Currently, there is a trend of incorporating antimicrobial agents into dental materials. The process has benefits such as the ability to prevent or reduce bacterial and fungal colonization by releasing agents [19]. The null hypothesis of the study was that silver–zeolite nanoparticles added to dental acrylic resins would not have an antimicrobial effect on saliva-contaminated dental acrylic and would not change its mechanical and physical properties. Based on the study’s analysis results, the null hypothesis of the study was rejected.
One of the most popular antimicrobial investigation method is colorimetric measurement with XTT. It converts live bacterial cells’ mitochondrial activities into tetrazolium salts that turn into a water-soluble orange formazan dye after the reaction [40,41]. The formazan products formed as a result of the rapid reaction are measured in the colorimetric spectrophotometer [30]. We used XTT colorimetric substrate in our study due to its numerous beneficial properties. In accordance with the scientific literature, we used a spectrophotometer to measure the optical density at 490 nm [6,42].
In Li et al.’s study, dental acrylic samples with 1%, 2%, 3%, and 5% silver were examined using a confocal scanning laser microscope. No significant effect was observed in the groups added at rates of 1%, 2%, and 3%, except for the 5% group which showed a significant decrease [43]. In a study, different concentrations (0–5%) of zeolite nanoparticles were added to heat-polymerized PMMA resin. Results showed that 2% zeolite addition rate was optimal for both mechanical and antimicrobial properties against C. albicans [44]. The results of this study are fully consistent with our findings. Our study concludes that the ideal nanoparticle concentration for optimum antimicrobial effect against C. albicans was 2%. In Casemiro et al.’s study, they added silver chino zeolite nanoparticles in varying concentrations (2.5%, 5%, 7.5%, 10%) to dental acrylic, and they reported that it had an antimicrobial effect against C. albicans and S. mutans strains [36]. Kuroki et al. found out that adding 1% silver–zeolite nanoparticles to dental acrylic reduced colonization of S. mutans compared to the control group [45]. We have found that adding silver nanoparticles to dental resin materials reduces bacterial and fungal colonization, similar to previous studies [46,47].
To minimize the risk of microbial attachment and plaque formation, it is crucial to properly finish and polish the external surfaces of prostheses. This is an essential step in the clinical protocol for fabricating the prostheses. After dentures are used in the oral environment, surface changes can occur, leading to the formation of rough surfaces that are more favorable for plaque accumulation. Therefore, regular maintenance and professional polishing of prosthetic surfaces are necessary to maintain oral hygiene and minimize the risk of oral infections. In our study, antimicrobial effect against C. albicans at 4% and 5% of nanoparticles concentration were lower than 2%. This is as a result of the surface roughness having increased with the nanoparticle concentration, and C. albicans can grow fast and adhere easily to rough surfaces [48,49]. However, in these groups, the number of Candida colonies decreased according to silver NPs’ concentration. Silver nanoparticle treatment has previously been reported to induce alterations in the cellular morphology of C. albicans, with inhibition of Candida hyphae formation [50]. The reason for the increase in absorbance may be due to the fact that Candida species develop hyphae by progressing towards ‘mycelial’ development during the incubation period [51]. Hyphae may have reduced the optical transmittance [51]. It is thought that it may have developed hyphae later in the experiment, and therefore, the absorbance may have increased.
Spectrophotometer values include the sum of viable and non-viable cells of the measured solution. However, the optical density measurement of cells is only an approximation of the colony count (CFU). Therefore, confirming with agar plate is an important control. The number of viable pathogens present in the suspension is determined by counting colony (CFU/mL) on agar plate [52,53]. As a result of our statistical analysis, a significant difference was observed between the groups in C. albicans. The number of C. albicans colonies had a significant decrease as nanoparticle percentages increased, but the fungal growth did not stop totally. A statistically significant difference was found among the groups tested for S. mutans (p < 0.001). Based on our analysis, we found that the addition of nanoparticles led to an increase in the antimicrobial effect, which was directly proportional to their concentration. There was a significant difference among the groups in the S. mutans bacteria. As a result of S. mutans colony count, it was seen that the growth stopped totally with silver NPs. Optical density measurements and medium count values with a spectrophotometer have resulted in supporting each other. In the study of Malic et al., 0.2, 0.4, 0.7, and 2% silver zeolite was added to dental acrylic, and they reported that it had an antimicrobial effect against C. albicans and S. mutans as a result of CFU count [4]. In Abe et al.’s study, silver zeolite was added to the tissue, resulting in a significant decrease in the number of C. albicans colonies [19]. Kuromi et al. counted the colony number to evaluate the antimicrobial effect of dental acrylic added with zeolite against S. mutans bacteria. It was reported that 1% added zeolite resulted in a significant decrease in the number of S. mutans colonies compared to the control group [45].
Micrometer and nanometer images of the samples are observed by SEM. In our study, we observed that the roughness of disc surfaces increased with silver NPs’ concentration as shown by SEM images of surface topography. We can state that the rough structure on the surface supports the colonization of yeast on the discs. Ranjitha et al. also studied the effects of 1% and 2% silver nanoparticle addition on surface roughness of heat-polymerized acrylic resin. They found higher surface roughness values in the 2% group compared with the 1% and control group as we reported in our study [29].
In order to confirm the presence of nanoparticles in PMMA, Aljafery and his colleagues reported the presence of silver and zinc synthesis forms of silver–zinc–zeolite nanoparticle added to dental acrylic by EDX analysis [47]. Nam et al. also incorporated silver, gold, and platinum to dental acrylic and visualized the presence of nanoparticles by SEM/EDX [54]. In the study conducted by Kasraei et al., silver nanoparticles were added to polymethylmethacrylate, and the presence of nanoparticles was examined by SEM/EDX [55]. In our study, we performed SEM/EDX analysis on one sample from each group before the test. Similarly, in our study we performed SEM/EDX analysis on one sample from each group before the test. The presence of silver was detected in all groups with the EDX images.
This study was conducted under in vitro conditions, which means that the results may differ from the in vivo activity. Therefore, it is important to carefully control the in vivo activities of silver NPs in clinical applications through animal models or human volunteers. The effect of thermal aging in the mouth was not evaluated in our study as a limitation. In order to support the clinical use of silver–zeolite NPs in dental acrylics, its biocompatibility can be investigated in further studies. Further studies are still required if the cations may precipitate within the oral epithelial cell for a long period of time, possibly causing argyria and disruption of normal microflora [56,57]. The results of Nam et al.’s study implicate that Ag-denture acrylic might act as a low-releasing antifungal device and therefore could help geriatric denture wearers who have restricted manual dexterity or cognitive disturbances to improve their oral hygiene status [12].
It is important to evaluate the mechanical properties of acrylic resins containing zeolites because removable and complete dentures are subjected to repeated forces [8]. Nevertheless, the addition of small percentages of zeolite to poly (methylmethacrylate) may be effective against microorganisms; therefore, its effect on mechanical properties may be less significant than the potential benefits, especially for patients who do not follow an adequate denture cleaning protocol [9,36,58].
Mechanical properties of the rectangular resin samples with 0, 2, 4, and 5% silver–zeolite nanoparticles were evaluated, and color change was also examined after the added nanoparticles. Researchers have been curiously looking for biocompatible nanomaterials to improve acrylic resins’ mechanical and biological properties [37]. The flexural strength of acrylic resin, also called the modulus of rupture, is the property that occurs when the prosthesis is subjected to cyclic deformation. It represents the highest stress experienced in this material at the moment of rupture. The low ability to withstand such deformation under force is the factor most responsible for the clinical incidence of early fracture of the prosthesis [59]. The frequent fracture of this material in the clinic may be due to low resistance to impact or bending forces [34]. Kamonkhantikul et al. evaluated the antimycotic, optical, and mechanical properties of different ratios of zinc oxide nanoparticles in thermosetting PMMA material [60]. Sodagar et al. found that SiO2 and TiO2 nanoparticles added at 0.5% and 0.1% decreased the flexural strength of acrylic resins [61]. In light of these studies, many methods have been tried to strengthen acrylic resin-based materials. In recent years, inorganic fillers containing various silver and silver ions have been used in different forms, such as silver–zirconium phosphate, silver–titanium dioxide, and silver–zeolite [62]. However, despite the antimicrobial advantages of the added modifying antimicrobial agents, their effect on the mechanical properties of the resins should also be evaluated [62]. Craig reported that the flexural strength test is the test that best simulates prostheses subjected to intraoral forces [63]. The flexural strength of materials is measured by uniaxial or biaxial testing with static and dynamic force loading. Today, the uniaxial three-point flexural test has been accepted as the standard test by ISO for acrylic resin materials due to its ease of application and reproducibility. This standard states that the minimum flexural strength values should be 65 MPa [64]. Azeez et al. [8] added 0.5% silver–zinc–zeolite nanoparticles to the heat-polymerized acrylic base material and reported a non-significant difference in the flexural strength test. They stated that the low ratio had little effect on the material. Casemiro et al. added silver–zinc–zeolite nanoparticles to heat-polymerized acrylic base material at 0, 2.5, 5, 7.5, and 10% ratios and applied a flexural strength test. They reported that the results of the mechanical tests indicated that the addition of zeolite may decrease the flexural and impact strength of acrylic resins in accordance with the findings of previous studies [36,65,66]. In the study by Murat et al., silver–zeolite nanoparticles were added to heat-polymerized acrylic at 0, 0.5, 2, and 4%, and flexural strength was evaluated. It was reported that the mechanical properties of microbial agents added to methacrylate were in line with similar studies and weakened the mechanical properties [65,66]. Yadav et al. reported that silver–zinc–zeolite added to acrylic resin at a rate of 5% caused lower flexural strength than 65 MPa specified in the ISO standard [67]. In this study, similar results were found, and the average value of silver–zeolite nanoparticles added at 2% was 65.40, while it decreased to 60.36 in the 5% group. The result in this study was partially similar to the result of Shibate et al. and Sodagar et al., who found that the flexural strength decreased as the percentage of nanoparticles increased [60,68].
It is thought that there is a decrease in flexural strength due to the effect of nano-sized oxides on the internal structure of the polymerized acrylic resin. In addition, the dispersion of the added nanoparticles in the PMMA matrix affects the conversion of monomers to polymer, resulting in an increase in unreacted residual monomers that act as plasticizers [60]. The addition of nanoparticles to acrylic resins causes the particles to aggregate and cluster together in the matrix, forming stress concentration zones and weakening the mechanical properties of the materials [66,69]. It should be considered that the decrease in flexural strength may also be due to the porous structure of the zeolite nanoparticle [46]. Unlike these studies, Kassae et al. reported that adding 0.5% silver nanoparticles did not cause a significant effect on the flexural strength of PMMA [70]. This result is thought to be due to the low nanoparticle ratio.
When an antibacterial agent was added, a color change in the denture base resin was reported due to the silver ion in the antibacterial agent [45,71]. Wakasa et al. reported that the addition of 1% and 2% silver–zeolite nanoparticles to autopolymerized acrylic resin did not affect the polymerization of the resin and discoloration of the dental material due to the silver in it [71]. Such a discoloration was reported to occur due to silver ions in the antimicrobial agent. It is believed that such discoloration is due to the oxidation of silver ions on the surface of the material as well as the formation of metal oxides from antibacterial metal ions during an oxidation–reduction reaction that occurs during polymerization [44]. In the study of Kuroki et al., 1% silver–zeolite nanoparticles were added to PMMA, and three color parameters (L*, a*, and b*) were measured using the CIE LAB color system color analysis method to examine the color change [45]. In line with these studies, the color differences between the groups in our study were quantitatively evaluated by averaging the measurements made from two points in a spectrophotometer device (Konica Minolta, Tokyo, Japan). Ren et al. used the CIE ΔE 2000 analysis for the evaluation of two different colors in dental acrylic [72]. In the present study, color analysis was performed with the CIE ΔE 2000 LAB color system, which is a more up-to-date approach. Wakasa et al. reported that the addition of 1% and 2% silver–zeolite nanoparticles to autopolymerized acrylic resin did not affect the polymerization of the resin and that the dental material changed color due to the silver content [30]. The color analysis findings of this study were similar to those of Wakasa et al. In another zeolite nanoparticle study, Kuroki et al. added 1% nanoparticles and reported a color change [32]. Azeez et al. added 0% and 0.5% silver–zinc–zeolite and concluded that both groups had a statistically insignificant difference in color change. They stated that this result was due to the fact that the percentage of zeolite added was less than 2% [8].
In another study by Malic and et al. [4], they showed that silver–zeolite nanoparticles added with increasing percentages caused intense brown coloration. They stated that this dark coloration is unacceptable for dental applications. They reported that silver zeolite treated with silver nitrate did not show such an intense coloration [4]. Therefore, silver nitrate-treated zeolite was preferred for this study. In this regard, it can be stated that coloration occurs, but nitrate treatment reduces the color change. Casemiro et al. added silver–zinc–zeolite nanoparticles to dental acrylic at 0, 2.5, 5, 7.5, and 10% and observed that the opacity of polymethylmethacrylate increased as the nanoparticle ratio increased [36]. In this study, similar to the results of the studies in the literature, it was observed that ΔE values changed as the percentage of nanoparticles added increased as a result of color analysis.
Paravina et al. reported 1.8 CIEΔE2000 units, which corresponds to the acceptability threshold of color differences for dentists [73]. Ren et al. reported that the 50% acceptability threshold for acrylic resin materials for denture bases was 4.08 CIEΔE2000 units [74]. Similar to this study, Alp et al. accepted the 50% acceptability threshold as 4.08 CIEΔE2000 units [75]. Color differences are graded with numbers from 1 to 5. ΔE00 and ΔEab based on perceptibility and acceptability thresholds are derived from value analysis research findings [73]. Grades 5 and 4 correspond to excellent (ΔE00 < 0.8) and acceptable color stability (>0.8 and <1.8), respectively. Grade 3 corresponds to the type of mismatch considered as moderate color mismatch (>1.8 and <3.6). Grade 2 corresponds to a clearly unacceptable color mismatch (>3.6 and <5.4), while grade 1 is considered a marked unacceptable mismatch (>5.4) [73]. According to the clinical acceptability of the ΔE2000 value [76,77], it can be stated that the 2% group has clinically acceptable results. The color changes of the 4% and 5% groups are not clinically acceptable values compared to the control group [73].
While the in vitro methodology used in this study offers precise control over experimental variables, it does not fully reflect the complex intraoral environment, especially due to the exclusion of thermal aging effects commonly encountered in the mouth. Such conditions, including temperature variations from food and beverages, significantly affect the longevity and performance of dental materials, a factor not accounted for in laboratory set-up. The findings of the current study need to be confirmed by in vivo studies. These subsequent investigations involving the multifaceted dynamics of the human oral cavity will prove the results’ applicability in a real-world clinical context, thus bridging the gap between laboratory research and practical dental application.
4. Materials and Methods
A mixture of pure PMMA powder and liquid monomer without silver–zeolite (Ag-Z) nanoparticles served as the control group. Silver–zeolite (Ag-Z) nanoparticles (Nanokar, Istanbul, Turkey) with a purity of 99.99% and a particle size of less than one μm were added in varying amounts: 0% (control), 2%, 4%, and 5% weighed with an analytical balance (Imıcryl, Konya, Turkey) and mixed with the acrylic in a Speed Mixer device (Imıcryl, Konya, Turkey) for 2 min at 1000 rpm by the same operator. The materials were then proportioned, mixed, packed and polymerized following the manufacturers’ instructions. Fifty-six disc-shaped specimens (12 × 2 mm) were prepared for the antimicrobial assay, and 40 bars (65 × 10 × 2.5 mm) were produced for testing optical and mechanical properties. These bar samples were fabricated into rectangular prisms, measuring 65 × 10 × 2.5 mm, in alignment with American Dental Association (ADA) No. 12 standards, and their dimensions were verified using calipers. A special wax (Kışlık, Istanbul, Türkiye) was melted into the molds to prepare rectangular-shaped patterns. The stainless steel disc and rectangular-shaped patterns were invested in flasks with dental stone. After the dental stone set, the flasks were opened and the patterns were removed, leaving rectangular-shaped and disc-shaped cavities that were used as matrixes for the fabrication of heat-polymerized acrylic resin specimens. The PMMA powder and liquid monomer (Imicryl, Konya, Türkiye) were mixed at a powder/liquid ratio of 23.4 g:10 mL and left until the mixture reached the dough stage. The mixture was then placed into the flask and hydraulic-pressed using a conventional method. The flasks were placed in a water bath that was heated up to 100 °C and allowed to boil for 45 min to achieve polymerization according to the recommendations. After cooling to room temperature, the specimens were deflasked, the excess material was removed using a carbide bur in a low-speed rotary instrument, and wet-polished using 800-, 1000-, 1200-, and 2000-grit silicon carbide paper with a polishing machine (Brightway, Bursa, Turkiye) at 300 rpm for 30 s. The thickness of all specimens was checked by measuring with an electronic caliper (Absolute Digimatic Caliper, Mitutoyo, Kawasaki, Japan). The specimens were ultrasonically cleaned for 5 min to remove any debris and dried with compressed air.
4.1. Antimicrobial Susceptibility Tests
Before microbial assay, samples were incubated in distilled water for 24 h to leach excess residual monomer. The disc specimens were autoclaved at 121 °C and 1 atm pressure in 20 min and then immersed in sterile artificial saliva. Artificial saliva was prepared at neutral pH (7–7.4), and chemicals were used as follows: 0.4 g of NaCl (Sigma-Aldrich, Darmstadt, Germany), 0.4 g of KCl (Sigma Aldrich, Germany), 0.795 g of CaCl2·2(H2O), 0.78 g of NaH2PO4·2(H2O), 0.0005 g of Na2S·9(H2O), 1 g of urea, and 1000 mL of distilled water. After the artificial saliva was prepared, it was sterilized in the autoclave and stored in the dark at room temperature
In this study, the standard strains ATCC 97012 C. albicans and RSHM 676 S. mutans were used to assess bacterial and fungal colonization on the surfaces of acrylic discs incorporating silver–zeolite nanoparticles. Tryptic soy broth (TSB) and Tryptic soy agar (TSA) (Biomerieux, Marcy l’Etoile, France) were used for S. mutans, while Sabouraud dextrose agar (SDA) and Sabouraud dextrose broth (SDB) (Sigma Aldrich, St. Louis, MO, USA) were used for C. albicans. All the cultural media were prepared according to the manufacturer’s recommendations and sterilized in an autoclave at 121 °C at 1 atm pressure for 20 min and transferred to the Petri dishes and tubes after cooling.
4.1.1. Contamination of Discs with Microorganisms
The discs were placed into sterile 6 × 4 cell culture dishes. For bacterial studies, 1 mL of Tryptic soy broth (TSB) was added to each well, and for fungal studies, 1 mL of Sabouraud dextrose broth (SDB) was used. To simulate the human oral environment, 1 mL of artificial saliva was also added to each well. Suspensions of bacterial and fungal colonies, adjusted to a 0.5 McFarland standard, were prepared in their respective culture media, and 1 mL of each suspension was added to the wells to contaminate the discs. Each study included one well as a sterility control and one as a growth control. The plates were then covered with parafilm and incubated for 24 h at 37 °C. After incubation, the liquid from each well was removed, and the discs were washed twice with 600 µL of PBS to eliminate non-adherent microorganisms. The discs were then re-contaminated and incubated for an additional 24 h.
4.1.2. Preparation of XTT and PMS Solutions
XTT (SERVA, Heidelberg, Germany) and Phenazine metasulfate (PMS) (Sigma Aldrich, USA) were dissolved in sterile Phosphate Buffer Solution (PBS) according to the manufacturer’s recommendations. All studies with XTT and PMS were performed in dark room conditions. The solutions were prepared fresh on the day of the study, covered with aluminum foil to avoid light, and stored in the dark. Then, 790 µL of PBS, 200 µL of XTT, and 10 µL of phenazine methosulfate PMS solution were added to each well and incubated at 37 °C for 3 h. After incubation, 100 µL of the solution from each well was transferred to a new sterile 12 × 8 cell culture plate using a sterile pipette tip.
4.1.3. Bacterial Colonization
Contamination of microorganisms on the discs were studied in several stages after all discs were contaminated with microorganisms. At first, the discs were taken from the wells and inoculated by moving them over the appropriate media. Secondly, the discs were transferred in broth media and incubated for 6 h at 37 °C. Following this, 10 µL of the sample was taken in each well and inoculated onto an agar plate for colony counting. Thirdly, after adding XTT and PMS solutions to the discs, bacterial concentrations were measured at 492 nm wavelengths using a spectrophotometer.
4.2. Optical Properties
Before optical and mechanical tests, forty bar specimens according to ADA specification No. 12 were incubated in distilled water for 48 h to leach excess residual monomer. To mimic the oral environment in vitro, all samples were kept in artificial saliva for 1 week in an oven (Nüve 1020, Ankara, Turkiye). The containers with artificial saliva were rinsed daily. The tested samples were exposed to light within a wavelength range of 380–780 nm via a measuring head positioned at a right angle. For each specimen, three repeated measurements were taken to determine the colorimetric values, i.e., L* (brightness), a* (red–green proportion), and b* (yellow–blue proportion). For color change, L, a, and b values were measured from two points on the smoothest surface with a spectrophotometer (Konica Minolta, Osaka, Japan) in the control group (0%) and samples containing silver–zeolite nanoparticles at 2, 4, and 5% ratios, and the values were averaged (Figure 11). The color change was calculated with the formula ΔE2000:
The parametric factors KL, KC, and KH were all set to 1. The mean of three readings was recorded, and the value of each specimen was calculated using the CIE-L*a*b*-color system with a colorimeter.
4.3. Mechanical Properties
After spectrophotometric evaluation, flexural strength was evaluated by a three-point bending using a Devotrans Device (Imicryl, Konya, Turkiye) to determine the flexural strength of the same forty bar-shaped specimens according to ADA specification No. 12 at 5 mm/min speed (Figure 12). The samples were placed on the apparatus, which was placed on supports parallel to each other and 50 mm apart. A load was applied until the specimen fractured. Flexural strength was calculated as follows:
where σ = flexural strength (N/mm2 = MPa), F = the maximum load during fracture (N), l = the distance between the supports (50 mm), b = the specimen width (mm), and d = specimen thickness (mm). Scanning electron microscope (SEM) analysis was performed via the SEM device FEI (Quanta 250 FEG; FEI Ltd., Brno, Czech Republic) at the Selcuk University Advanced Technology Research and Application Center.
σ = 3Fl\2bd2
Scanning Electron Microscope (SEM)
Fractured surfaces of the bar-shaped specimens of the control and other groups after the three-point bending test were randomly selected, gold-sputter-coated, and observed using SEM (Quanta 250; FEI Company, Eindhoven, The Netherlands) under acceleration of 20 kV and magnification of 35,000×.
4.4. Statistical Analysis
One-way Analysis of Variance (ANOVA) test was used to determine the significant difference between groups. When there was a significant difference, Tukey HSD and Tamhane’s T2 tests were used for multiple comparisons to identify specific differences between groups. These tests offer a significant determination of the relations among various groups in the field of microbiological research. The data analysis was performed using IBM SPSS V23 software. The Shapiro–Wilk test was used to assess normal distribution conformity with a significance level of p < 0.05.
5. Conclusions
Three different rates of nanoparticles (0%, 2%, 4%, 5%) were added to the heat-polymerized acrylic resin used as the denture base material. In vitro antimicrobial effects of nanoparticles were investigated against C. albicans and S. mutans strains. The surfaces of the samples were analyzed using topographic imaging to determine their level of surface roughness. The presence of silver nanoparticles was evaluated using SEM/EDX imaging.
According to the spectrophotometer analysis, discs with 2% silver–zeolite nanoparticles were more effective against C. albicans than those with 4% and 5%. Discs with 2% silver–zeolite nanoparticles showed a significant antimicrobial effect compared to the 0% group. The reason for the increase in colonization of C. albicans in the 4% and 5% groups can be attributed to the increased surface roughness. The concentration of nanoparticles had a significant impact on the decrease of S. mutans colonization. Based on its antimicrobial and mechanical properties, we recommend adding 2% silver–zeolite nanoparticles to the acrylic resin material used for denture base material for optimal results. While adding silver–zeolite nanoparticles provides antimicrobial properties, it also reduces the material’s structural integrity and alters its aesthetic appearance, highlighting the necessity of balancing antimicrobial efficacy with mechanical and esthetic properties in dental materials. In the current study, it was found that the addition of 2% silver nitrate-treated zeolite nanoparticles to acrylic material used in dental prostheses was satisfactory in terms of both discoloration and mechanical strength, i.e., the acrylic material was discolored at an acceptable level, and its mechanical strength remained adequate. However, when the amount of nanoparticles was increased to 5%, the strength of the material decreased significantly, i.e., the material became weaker. Specimens prepared with nanoparticles added at 2% and 4% were found to be clinically suitable with a strength value of 65.40 MPa. Moreover, as the proportion of nanoparticles added to increase the antimicrobial properties increased, an increase in the color of the material was also observed. However, the silver–zeolite nanoparticles added at 2% were still within clinically acceptable limits regarding color change. As a clinical significance; it is advisable to incorporate 2% silver–zeolite nanoparticles into the material of acrylic dental prostheses to impart antimicrobial features while preserving a balance between mechanical and aesthetic properties. Therefore, this will make the acrylic dentures more durable and reduce microbial growth, providing both an aesthetic and functional solution.
Author Contributions
Conceptualization, N.D. and U.A.; data curation, Ç.K.Y.; investigation, Ç.K.Y., N.D., U.A. and N.Ç.; methodology, Ç.K.Y., U.A. and N.Ç.; project administration, N.D.; supervision, N.D. and U.A.; writing—original draft preparation, Ç.K.Y. and N.Ç.; writing—review and editing, N.D. and N.Ç. All authors have read and agreed to the published version of the manuscript.
Funding
The research leading to these results received funding from Selcuk University Science Research Thesis Projects (under Grant Agreement No: 21212060).
Institutional Review Board Statement
The authors state that they have obtained appropriate institutional review board approval or have followed the principles outlined in the Declaration of Helsinki for all human or animal experimental investigations. This study was conducted with Selcuk University Medical Faculty Ethical Committee approval with decision No: 2022/18. The manuscript does not report on or involve any animals, humans, human data, human tissue or plants for consent to participate.
Data Availability Statement
The original contributions presented in the study are included in the article, further inquiries can be directed to the corresponding author.
Acknowledgments
The researchers appreciate Murat Aydin (who has a doctorate degree from the microbiology department) for his contributions to this research study.
Conflicts of Interest
The authors have no other relevant affiliations or financial involvement with any organization or entity with a financial interest in or financial conflict with the subject matter or materials discussed in the manuscript apart from those disclosed. This includes employment, consultancies, honoraria, stock ownership or options, expert testimony, grants or patents received or pending, or royalties.
References
- Price, C. A history of dental polymers. Aust. Prosthodont. J. 1994, 8, 47–54. [Google Scholar] [PubMed]
- Lessa, F.C.R.; Enoki, C.; Ito, I.Y.; Faria, G.; Matsumoto, M.A.N.; Nelson-Filho, P. In-vivo evaluation of the bacterial contamination and disinfection of acrylic baseplates of removable orthodontic appliances. Am. J. Orthod. Dentofac. Orthop. 2007, 131, 705.e11–705.e17. [Google Scholar] [CrossRef] [PubMed]
- Rickman, L.J.; Padipatvuthikul, P.; Satterthwaite, J.D. Contemporary denture base resins: Part 1. Dent. Update 2012, 39, 25–28. [Google Scholar] [CrossRef] [PubMed]
- Malic, S.; Rai, S.; Redfern, J.; Pritchett, J.; Liauw, C.M.; Verran, J.; Tosheva, L. Zeolite-embedded silver extends antimicrobial activity of dental acrylics. Colloids Surf. B Biointerfaces 2019, 173, 52–57. [Google Scholar] [CrossRef] [PubMed]
- Sumi, Y.; Miura, H.; Michiwaki, Y.; Nagaosa, S.; Nagaya, M. Colonization of dental plaque by respiratory pathogens in dependent elderly. Arch. Gerontol. Geriatr. 2007, 44, 119–124. [Google Scholar] [CrossRef]
- Wady, A.; Machado, A.L.; Zucolotto, V.; Zamperini, C.; Berni, E.; Vergani, C.E. Evaluation of Candida albicans adhesion and biofilm formation on a denture base acrylic resin containing silver nanoparticles. J. Appl. Microbiol. 2012, 112, 1163–1172. [Google Scholar] [CrossRef]
- Valentini, F.; Luz, M.S.; Boscato, N.; Pereira-Cenci, T. Biofilm formation on denture liners in a randomised controlled in situ trial. J. Dent. 2013, 41, 420–427. [Google Scholar]
- Azeez, Z.A.; Fatah, N.A. The effect of incorporation of prepared Ag-Zn Zeolite on some properties of heat polymerized acrylic denture base materials. J. Baghdad Coll. Dent. 2015, 27, 63–69. [Google Scholar] [CrossRef]
- Saengmee-Anupharb, S.; Srikhirin, T.; Thaweboon, B.; Thaweboon, S.; Amornsakchai, T.; Dechkunakorn, S.; Suddhasthira, T. Antimicrobial effects of silver zeolite, silver zirconium phosphate silicate and silver zirconium phosphate against oral microorganisms. Asian Pac. J. Trop. Biomed. 2013, 3, 47–52. [Google Scholar] [CrossRef]
- Schneid, T.R. An in vitro analysis of a sustained release system for the treatment of denture stomatitis. Spec. Care Dent. 1992, 12, 245–250. [Google Scholar]
- Budtz-Jørgensen, E.; Mojon, P.; Banon-Clément, J.M.; Baehni, P. Oral candidiasis in long-term hospital care: Comparison of edentulous and dentate subjects. Oral Dis. 1996, 2, 285–290. [Google Scholar] [CrossRef] [PubMed]
- Nam, K.Y.; Lee, C.H.; Lee, C.J. Antifungal and physical characteristics of modified denture base acrylic incorporated with silver nanoparticles. Gerodontology 2012, 29, e413–e419. [Google Scholar]
- Buergers, R.; Rosentritt, M.; Handel, G. Bacterial adhesion of Streptococcus mutans to provisional fixed prosthodontic material. J. Prosthet. Dent. 2007, 98, 461–469. [Google Scholar] [PubMed]
- McCarthy, C.; Snyder, M.; Parker, R. The indigenous oral flora of man-I: The newborn to the 1-year-old infant. Arch. Oral Biol. 1965, 10, 61–70. [Google Scholar] [CrossRef] [PubMed]
- Paster, B.J.; Olsen, I.; Aas, J.A.; Dewhirst, F.E. The breadth of bacterial diversity in the human periodontal pocket and other oral sites. Periodontology 2006, 42, 80–87. [Google Scholar]
- Albandar, J.; Brunelle, J.; Kingman, A. Destructive periodontal disease in adults 30 years of age and older in the United States. J. Periodontol. 1999, 70, 13–29. [Google Scholar]
- Uçar, Y.; Bakar, O.; Ekinci, M.; Kayar, B. Poliamid ile farklı polimetilmetakrilat protez kaide materyallerinin mikroorganizma tutulumunun karşılaştırılması. SDÜ Tıp Fak. Derg. 2013, 20, 8–13. [Google Scholar]
- Li, L.; Redding, S.; Dongari-Bagtzoglou, A. Candida glabrata, an emerging oral opportunistic pathogen. J. Dent. Res. 2007, 86, 204–215. [Google Scholar]
- Abe, Y.; Ishii, M.; Takeuchi, M.; Ueshige, M.; Tanaka, S.; Akagawa, Y. Effect of saliva on an antimicrobial tissue conditioner containing silver–zeolite. J. Oral Rehabil. 2004, 31, 568–573. [Google Scholar] [CrossRef]
- Alla, R.; Raghavendra, K.; Vyas, R.; Konakanchi, A. Conventional and contemporary polymers for the fabrication of denture prosthesis: Part I–overview, composition and properties. Int. J. Appl. Dent. Sci. 2015, 1, 82–89. [Google Scholar]
- Galav, A.; Deogade, S.C.; Mantri, S.; Sumathi, K.; Galav, S. Effect of water storage on the flexural strength of heat-cured denture base resin reinforced with stick(s) glass fibers. Contemp. Clin. Dent. 2017, 8, 264–271. [Google Scholar] [PubMed]
- Khosravani, M.R. Mechanical behavior of restorative dental composites under various loading conditions. J. Mech. Behav. Biomed. Mater. 2019, 93, 151–157. [Google Scholar] [CrossRef] [PubMed]
- Gad, M.M.; Fouda, S.M.; Al-Harbi, F.A.; Näpänkangas, R.; Raustia, A.N. PMMA denture base material enhancement: A review of fiber, filler, and nanofiller addition. Int. J. Nanomed. 2017, 12, 3801–3812. [Google Scholar] [CrossRef] [PubMed]
- Oka, H.; Tomioka, T.; Tomita, K.; Nishino, A.; Ueda, S. Inactivation of enveloped viruses by a silver-thiosulfate complex. Met. Drugs 1994, 1, 511. [Google Scholar] [CrossRef] [PubMed]
- Tokumaru, T.; Shimizu, Y.; Fox, J.R.C. Antiviral activities of silver sulfadiazine in ocular infection. Res. Commun. Chem. Pathol. Pharmacol. 1974, 8, 151–158. [Google Scholar]
- Alt, V.; Bechert, T.; Steinrucke, P.; Wagener, M.; Seidel, P.; Dingeldein, E.; Domann, E.; Schnettler, R. An in vitro assessment of the antibacterial properties and cytotoxicity of the nanoparticles silver bone cement. Biomaterials 2004, 25, 4383–4391. [Google Scholar] [CrossRef]
- Samuel, U.; Guggenbichler, J.P. Prevention of catheter- related infections: The potential of a new nanosilver impregnated catheter. Int. J. Antimicrob. Agents 2004, 23, 75–78. [Google Scholar] [CrossRef]
- Wright, J.B.; Lam, K.; Hansen, D.; Burrell, R. Efficacy of topical silver against fungal burn wound pathogens. Am. J. Infect. Control 1999, 27, 344–350. [Google Scholar] [CrossRef]
- Ranjitha, V.; Reddy, K.M.; Shastry, Y.M. Effects of silver nanoparticles addition on flexural strength and surface roughness of heat polymerized acrylic resin-An in-vitro study. J. Adv. Med. Dent. Sci. Res. 2022, 10, 87–91. [Google Scholar]
- Nikawa, H.; Yamamoto, T.; Hamada, T.; Rahardjo, M.; Murata, H.; Nakanoda, S. Antifungal effect of zeolite-incorporated tissue conditioner against Candida albicans growth and/or acid production. J. Oral Rehabil. 1997, 24, 350–357. [Google Scholar]
- Feng, Q.L.; Wu, J.; Chen, G.Q.; Cui, F.; Kim, T.; Kim, J.A. mechanistic study of the antibacterial effect of silver ions on Escherichia coli and Staphylococcus aureus. Biomed. Mater. Res. 2000, 52, 662–668. [Google Scholar] [CrossRef]
- Cheun, K. Antibacterial activity of A-type zeolite supporting silver ions in deionized distilled water. J. Antibact. Antifung. Agent. 1996, 24, 269–274. [Google Scholar]
- Inoue, Y.; Hoshino, M.; Takahashi, H.; Noguchi, T.; Murata, T.; Kanzaki, Y.; Hamashima, H.; Sasatsu, M. Bactericidal activity of Ag–zeolite mediated by reactive oxygen species under aerated conditions. J. Inorgan. Biochem. 2002, 92, 37–42. [Google Scholar]
- Asar, N.V.; Albayrak, H.; Korkmaz, T.; Turkyilmaz, I. Influence of various metal oxides on mechanical and physical properties of heat-cured polymethyl methacrylate denture base resins. J. Adv. Prosthodont. 2013, 5, 241–247. [Google Scholar] [CrossRef]
- Abdulridha, W.M.; Almusawi, R.M.; Al-Jubouri, O.M.; Wally, Z.J.; Zidan, S.; Haider, J.; Al-Quraine, N.T. Studying the effect of adding Titanium Dioxide (TiO2) nanoparticles on the compressive strength of chemical and heat-activated acrylic denture base resins. Adv. Mater. Process. Technol. 2020, 8, 1058–1070. [Google Scholar] [CrossRef]
- Casemiro, L.A.; Martins, C.H.G.; Pires-de-Souza, F.C.P.; Panzeri, H. Antimicrobial and mechanical properties of acrylic resins with incorporated silver-zinc zeolite part I. Gerodontology 2008, 25, 187–194. [Google Scholar] [CrossRef]
- de Souza Leão, R.; de Moraes, S.L.D.; de Luna Gomes, J.M.; Lemos, C.A.A.; da Silva Casado, B.G.; do Egito Vasconcelos, B.C.; Pellizzer, E.P. Influence of addition of zirconia on PMMA: A systematic review. Mater. Sci. Eng. C 2020, 106, 110292. [Google Scholar]
- Darwish, M.; Nassani, M.Z. Evaluation of the effect of denture adhesives on surface roughness of two chemically different denture base resins. Eur. J. Dent. 2016, 10, 321–326. [Google Scholar] [CrossRef][Green Version]
- Keng, S.B.; Lim, M. Denture plaque distribution and the effectiveness of a perborate-containing denture cleanser. Quintessen Intern. 1996, 27, 341–345. [Google Scholar]
- Sen, B.H.; Chugal, N.M.; Liu, H.; Fleischmann, J.A. new method for studying the adhesion of Candida albicans to dentin in the presence or absence of smear layer. Oral Surg. Oral Med. Oral Pathol. Oral Radiol. Endodontology 2003, 96, 201–206. [Google Scholar]
- Koban, I.; Matthes, R.; Hübner, N.O.; Welk, A.; Sietmann, R.; Lademann, J.; Kramer, A.; Kocher, T. XTT assay of ex vivo saliva biofilms to test antimicrobial influences. GMS Krankenhaushygiene Interdiszip. 2012, 7. [Google Scholar] [CrossRef]
- Ozel, G.S.; Guneser, M.B.; Inan, O.; Eldeniz, A.U. Evaluation of C. albicans and S. mutans adherence on different provisional crown materials. J. Adv. Prosthodont. 2017, 9, 335–340. [Google Scholar] [CrossRef] [PubMed]
- Li, Z.; Sun, J.; Lan, J.; Qi, Q. Effect of a denture base acrylic resin containing silver nanoparticles on Candida albicans adhesion and biofilm formation. Gerodontology 2016, 3, 209–216. [Google Scholar] [CrossRef] [PubMed]
- Nakanoda, S.; Nikawa, H.; Hamada, T.; Yamamoto, T.; Nakamoto, K. The material and antifungal properties of antibiotic zeolite incorporated acrylic resin. J. Jpn. Prosthodont. Soc. 1995, 39, 919–926. [Google Scholar] [CrossRef]
- Kuroki, K.; Hayashi, T.; Sato, K.; Asai, T.; Okano, M.; Kominami, Y.; Takahashi, Y.; Kawai, T. Effect of self-cured acrylic resin added with an inorganic antibacterial agent on Streptococcus mutans. Dent. Mater. J. 2010, 29, 277–285. [Google Scholar] [CrossRef]
- Dao, P.H.; Nguyen, T.D.; Nguyen, T.C.; Nguyen, A.H.; Mac, V.P.; Tran, H.T.; Phung, T.L.; Vu, Q.T.; Vu, D.H.; Ngo, T.C.Q.; et al. Assessment of some characteristics, properties of a novel waterborne acrylic coating incorporated TiO2 nanoparticles modified with silane coupling agent and Ag/Zn zeolite. Prog. Org. Coat. 2022, 163, 106641. [Google Scholar] [CrossRef]
- Aljafery, A.M.; Al-Jubouri, O.M.; Wally, Z.J.; Almusawi, R.M.; Abdulrudha, N.H.; Haider, J. The Effects of Incorporating Ag-Zn Zeolite on the Surface Roughness and Hardness of Heat and Cold Cure Acrylic Resins. J. Compos. Sci. 2022, 6, 85. [Google Scholar] [CrossRef]
- Karcı, M.; Demir, N.; Yazman, Ş. Farklı Nanopartiküllerle Güçlendirilen Mikrodalga Enerjisi İle Polimerize Olan Akrilik Rezinin Mekanik Ve Fiziksel Özelliklerinin Değerlendirilmesi. Atatürk Üniversitesi Diş Hekim. Fakültesi Derg. 2017, 30, 101–106. [Google Scholar]
- Karamustafa, F. Akrilik Rezin Materyallerine Farklı Oranlarda çay Ağacı Yağı Eklenmesinin Candida Albicans İnhibisyonuna ve Materyallerin Yüzey Pürüzlülüğüne Etkisi. Ph.D. Thesis, Karadeniz Teknik Üniversitesi, Trabzon, Türkiye, 2021. [Google Scholar]
- Khatoon, N.; Sharma, Y.; Sardar, M.; Manzoor, N. Mode of action and anti-Candida activity of Artemisia annuamediated-synthesized silver nanoparticles. J. Mycol. Med. 2019, 29, 201–209. [Google Scholar] [CrossRef]
- Haque, F.; Alfatah, M.; Ganesan, K.; Bhattacharyya, M.S. Inhibitory effect of sophorolipid on Candida albicans biofilm formation and hyphal growth. Sci. Rep. 2016, 6, 235–275. [Google Scholar] [CrossRef]
- Jimenez, L.; Ignar, R.; Smalls, S.; Grech, P.; Hamilton, J.; Bosko, Y.; English, D. Molecular detection of bacterial indicators in cosmetic/pharmaceuticals and raw materials. J. Ind. Microbiol. Biotechnol. 1999, 22, 93–95. [Google Scholar] [CrossRef]
- Huang, J.; Hitchins, A.D.; Tran, T.T.; McCarron, J.E. Bacteriological Analytical Manual Chapter 23: Methods for Cosmetics. July 2024 Edition. pp. 1–15. Available online: https://www.fda.gov/media/177960/download (accessed on 22 September 2024).
- Nam, K.Y. Characterization and antifungal activity of the modified PMMA denture base acrylic: Nanocomposites impregnated with gold, platinum, and silver nanoparticles. Nanobiomater. Dent. 2016, 11, 309–336. [Google Scholar]
- Kasraei, S.; Azarsina, M. Addition of silver nanoparticles reduces the wettability of methacrylate and silorane-based composites. Br. Dent. J. 2012, 26, 505–510. [Google Scholar] [CrossRef] [PubMed]
- Petering, H.G. Pharmacology and toxicology of heavy metals: Silver. Pharmacol. Ther. 1976, 1, 127–130. [Google Scholar] [CrossRef]
- Ramage, G.; Vande Walle, K.; Wickes, B.L.; López-Ribot, J.L. Standardized method for in vitro antifungal susceptibility testing of Candida albicans biofilms. Antimicrob. Agents Chemother. 2001, 45, 2475–2479. [Google Scholar] [CrossRef]
- Mutneja, P.; Raghavendraswamy, K.N.; Gujjari, A.K. Flexural strength of heat cure acrylic resin after incorporation of different percentage of Silver zinc zeolite- an in-vitro study. IJCI 2013, 4, 25–31. [Google Scholar]
- Takahashi, T.; Gonda, T.; Maeda, Y. The influence of reinforcement on strain in maxillary complete dentures: A preliminary report. Int. J. Prosthodont. 2011, 24, 273–276. [Google Scholar]
- Kamonkhantikul, K.; Arksornnukit, M.; Takahashi, H. Antifungal, optical, and mechanical properties of polymethylmethacrylate material incorporated with silanized zinc oxide nanoparticles. Int. J. Nanomed. 2017, 12, 2353–2360. [Google Scholar] [CrossRef]
- Sodagar, A.; Khalil, S.; Kassaee, M.Z.; Shahroudi, A.S.; Pourakbari, B.; Bahador, A. Antimicrobial properties of poly (methyl methacrylate) acrylic resins incorporated with silicon dioxide and titanium dioxide nanoparticles on cariogenic bacteria. J. Orthodont. Sci. 2016, 5, 7. [Google Scholar]
- Ferreira, L.; Guedes, J.F.; Almeida-Aguiar, C.; Fonseca, A.M.; Neves, I.C. Microbial growth inhibition caused by Zn/Ag-Y zeolite materials with different amounts of silver. Colloids Surf. B Biointerfaces 2016, 142, 141–147. [Google Scholar] [CrossRef]
- Craig, R.G.P.J.; Wataha, J.C. Dental Polymers. In Dent Mater, Properties and Manipulation, 11th ed.; C. V. Mosby Company: St. Louis, MO, USA, 2001. [Google Scholar]
- Standardization of Dentistry: Denture Base Polymer; International Organization for Standardization: Geneva, Switzerland, 1999.
- Addy, M.; Handley, R. The effects of the incorporation of chlorhexidine acetate on some physical properties of polymerized and plasticized acrylics. J. Oral Rehabil. 1981, 8, 155–163. [Google Scholar] [CrossRef] [PubMed]
- Murat, S. Gümüş zeolit ilave edilen akrilik rezinlerin eğilme dayanimlarinin in-vitro değerlendirilmesi. Atatürk Ünv. Diş Hek. Fak. Derg. 2018, 4, 539–544. [Google Scholar]
- Yadav, N.S.; Saraf, S.; Mishra, S.K.; Hazari, P. Effects of fluconazole, chlorhexidine gluconate, and silver-zinc zeolite on flexural strength of heat-cured polymethyl methacrylate resin. J. Nat. Sci. Biol. Med. 2015, 6, 340. [Google Scholar]
- Shibata, T.; Hamada, N.; Kimoto, K.; Sawada, T.; Kumada, H.; Umemoto, T.; Toyoda, M. Antifungal effect of acrylic resin containing apatite-coated TiO2 photocatalyst. Dent. Mater. J. 2007, 26, 437–444. [Google Scholar] [CrossRef] [PubMed]
- Shan, Y.; Bai, Y.; Yang, S.; Zhou, Q.; Wang, G.; Zhu, B.; Zhou, Y.; Fang, W.; Wen, N.; He, R.; et al. 3D-printed strontium-incorporated β-TCP bioceramic triply periodic minimal surface scaffolds with simultaneous high porosity, enhanced strength, and excellent bioactivity. J. Adv. Ceram. 2023, 12, 1671–1684. [Google Scholar] [CrossRef]
- Kassaee, M.; Akhavan, A.; Sheikh, N.; Sodagar, A. Antibacterial effects of a new dental acrylic resin containing silver nanoparticles. J. Appl. Polym. Sci. 2008, 110, 1699–1703. [Google Scholar] [CrossRef]
- Wakasa, K. A fundamental study on dental application of silver zeolite. J. Hiroshima Univ. Dent. Soc. 1997, 29, 87–98. [Google Scholar]
- Ren, J.; Lin, H.; Huang, Q.; Liang, Q.; Zheng, G. Color difference threshold determination for acrylic denture base resins. Bio-Med. Mater. Eng. 2015, 26, S35–S43. [Google Scholar] [CrossRef]
- Paravina, R.D.; Ghinea, R.; Herrera, L.J.; Bona, A.D.; Igiel, C.; Linninger, M.; Sakai, M.; Takahashi, H.; Tashkandi, E.; Perez, M.d.M. Color difference thresholds in dentistry. J. Esthet. Restor. Dent. 2015, 27, S1–S9. [Google Scholar] [CrossRef]
- Ren, J.; Lin, H.; Huang, Q.; Zheng, G. Determining color difference thresholds in denture base acrylic resin. J. Prosthet. Dent. 2015, 114, 702–708. [Google Scholar] [CrossRef]
- Alp, G.; Johnston, W.M.; Yilmaz, B. Optical properties and surface roughness of prepolymerized poly (methyl methacrylate) denture base materials. J. Prosthet. Dent. 2019, 121, 347–352. [Google Scholar] [CrossRef] [PubMed]
- O’brien, W.J. Dental Materials and Their Selection; Quintessence: Carol Stream, IL, USA, 2002. [Google Scholar]
- Yilmaz, B.; Karaagaclioglu, L. In vitro evaluation of color replication of metal ceramic specimens using visual and instrumental color determinations. J. Prosthet. Dent. 2011, 105, 21–27. [Google Scholar] [CrossRef] [PubMed]
Disclaimer/Publisher’s Note: The statements, opinions and data contained in all publications are solely those of the individual author(s) and contributor(s) and not of MDPI and/or the editor(s). MDPI and/or the editor(s) disclaim responsibility for any injury to people or property resulting from any ideas, methods, instructions or products referred to in the content. |
© 2024 by the authors. Licensee MDPI, Basel, Switzerland. This article is an open access article distributed under the terms and conditions of the Creative Commons Attribution (CC BY) license (https://creativecommons.org/licenses/by/4.0/).